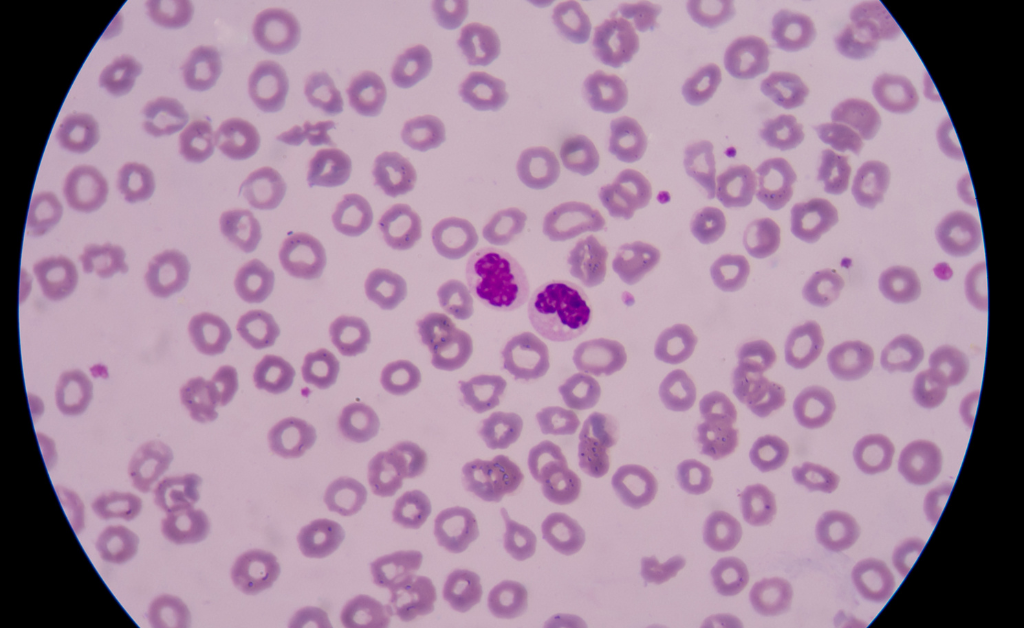

DR. Maheswari, MBBS., DGO., FCD
Dr. N.G. Maheswari is a compassionate obstetrician and gynaecologist with extensive training and experience in women's health. She completed her MBBS at Rajah Muthiah Medical College, Chidambaram, where she developed a strong foundation in general medicine. Pursuing her passion for women’s health, she earned a Diploma in Gynaecology and Obstetrics (DGO)
Area of Expertise

DR. Palanichamy, MBBS., DCH
Dr. Palanichamy is a dedicated consultant paediatrician with a wealth of experience in providing comprehensive care for children. He completed his MBBS at Madurai Medical College, where he developed a strong foundation in medical practice. Following this, he pursued a Diploma in Child Health (DCH) at the Institute of Child Health in Chennai, further specializing in paediatric care.
Area of Expertise

Dr. Suresh Kumar., (MD) – General medicine

Dr. Sailesh., (MS) – General surgery